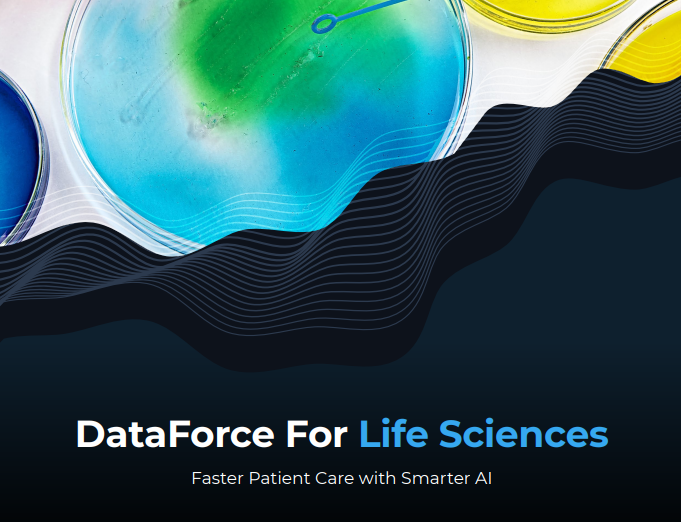
df-lifesci

IA mais inteligente com a DataForce da TransPerfect
A DataForce é líder global em serviços de ampliação e anotação de dados, combinando modelos de entrega seguros, flexíveis e escaláveis com as plataformas de gestão de recursos e anotações mais poderosas do mundo.
- Coleta e anotação de áudio
- Coleta e anotação de textos
- Coleta e anotação de imagens
- Coleta e anotação de vídeos
- Localização de chatbot
Esteja você desenvolvendo uma solução de IA para processamento de linguagem natural (Natural Language Processing, NLP) visão computacional ou conversação, podemos coletar e analisar dados usando os processos e ferramentas mais ágeis para completar seu conjunto de dados, reduzir a parcialidade e adicionar identificadores.
- Garantia de qualidade
- Gestão de projetos e de programas
- Abordagem que prioriza o cliente
- Integração com várias plataformas
Tanto a coleta quanto o enriquecimento de dados podem ser realizados em nossas ferramentas proprietárias, assim como em ferramentas de segurança móvel ou baseadas na web, mas também usamos frequentemente as plataformas de nossos clientes.
- 1.000.000 de anotadores
- 250 idiomas
- Anotadores especializados por setor
- Coleta e anotação de dados
- Estudos e teste da experiência do usuário
A segurança é uma prioridade na TransPerfect. Com uma infraestrutura privada certificada, seus dados confidenciais estão seguros e protegidos.
- Conformidade com o RGPD
- Certificação ISO 27001
- SOC 2
- HIPAA
- Implementação de políticas específicas dos clientes
IA mais inteligente em todos os idiomas

A DataForce pode coletar dados de voz personalizados em mais de 200 idiomas. Nosso grupo demograficamente diversificado e cuidadosamente selecionado pode fornecer gravações de áudio na sua plataforma preferida, incluindo mais de 40 marcas de telefones celulares. Também podemos trabalhar com dispositivos personalizados e exclusivos.
Após coletar os dados, revisamos a qualidade e categorizamos, transcrevemos e entregamos aos nossos clientes por meio de fluxos de dados acessíveis e bem definidos.
Nossos fluxos de trabalho habilitados por machine learning podem anonimizar o áudio antes de ele ser enviado aos transcritores para que haja um mecanismo extra de segurança.
Para mais informações, consulte nossos estudos de casos que descrevem alguns de nossos projetos de gravação de áudio e transcrição.

Para desenvolver os serviços, os produtos e as experiências do futuro, as organizações precisam usar seus dados de texto. Isso inclui documentos, relatórios, e-mails e outras fontes de dados estruturados ou semiestruturados. Não importa se você está desenvolvendo soluções de IA para medicina de precisão, gestão de riscos ou de conversação, poder treinar seus modelos em dados identificados com precisão é o caminho mais confiável para uma implantação bem-sucedida.
Nossos anotadores especialistas e treinados têm acesso a ferramentas de anotação de última geração. Isso combinado com KPIs ajustados e processos de garantia de qualidade faz com que possamos oferecer as melhores anotações em qualquer tema ou setor.

A visão computacional está entre as tecnologias de IA mais populares e de mais rápida adoção. A DataForce desenvolveu uma lista de serviços e tecnologias especializados para apoiar suas aplicações inovadoras, incluindo:
- Coleta de imagens e vídeos personalizados representando demografias variadas, todos os locais possíveis (internos e ao ar livre), várias opções de hardware e sensores para várias aplicações, como produtos de consumo, aplicativos móveis, dispositivos médicos, carros autônomos ou monitoramento do comportamento do consumidor.
- Anotação de imagens e vídeos com caixas delimitadoras, segmentação semântica, objetos 3D e LIDAR.
- Legenda de imagens e vídeos, sempre usando a gramática e o estilo corretos, com consistência em todos os casos de uso e idiomas.
Todos os nossos recursos na área de visão computacional têm algo em comum:
- Excelente atendimento ao cliente.
- Fluxos de trabalho seguros.
- Transparência total relativa a procedimentos de privacidade e qualidade.
- Anotadores selecionados cuidadosamente e treinados.
- Proporção qualidade/preço ideal.

A DataForce desenvolveu um processo exclusivo de localização de ponta a ponta, adaptado às necessidades dos sistemas conversacionais. De dados de treinamento de alta qualidade e desenvolvimento gramatical à transcriação das respostas do sistema, garantimos que o seu chatbot ou assistente virtual será:
- Fluente.
- Específico para a marca.
- Sensível à cultura.
- Em conformidade com os requisitos regulatórios necessários do público-alvo de seu mercado.
Além de nossos serviços de dados e de idiomas, nossos serviços de teste e experiência do usuário ajudarão você a implantar sua solução de IA de conversação com confiança em qualquer mercado ou ambiente – inclusive carros, eletrodomésticos, sites ou aplicativos móveis.

Muitas organizações implantaram o human-in-the-loop (HITL) para ajudar a aprimorar seus produtos, recursos e algoritmos de pesquisa. Esse processo envolve coletar percepções e medições de pessoas para treinar, medir e otimizar a relevância e qualidade dos resultados para os usuários finais e criar uma melhor experiência do usuário.
O aprimoramento e o treinamento de algoritmos de pesquisa dependem de muitos sinais de relevância e exigem grandes quantidades de dados de treinamento. Isso é especialmente verdadeiro quando os produtos são internacionais e suportam vários idiomas e mercados. Esses avaliadores humanos podem identificar, anotar ou classificar grandes volumes de consultas de pesquisa com seus resultados correspondentes para gerar insights significativos que ajudam a melhorar os padrões de relevância e a qualidade dos algoritmos de pesquisa.
A DataForce gerencia esse tipo de trabalho em uma plataforma segura usando uma comunidade selecionada de avaliadores humanos.
Além da relevância da pesquisa, nosso serviço abrange a relevância de anúncios, relevância de recomendações e outros tipos de moderação de conteúdo.